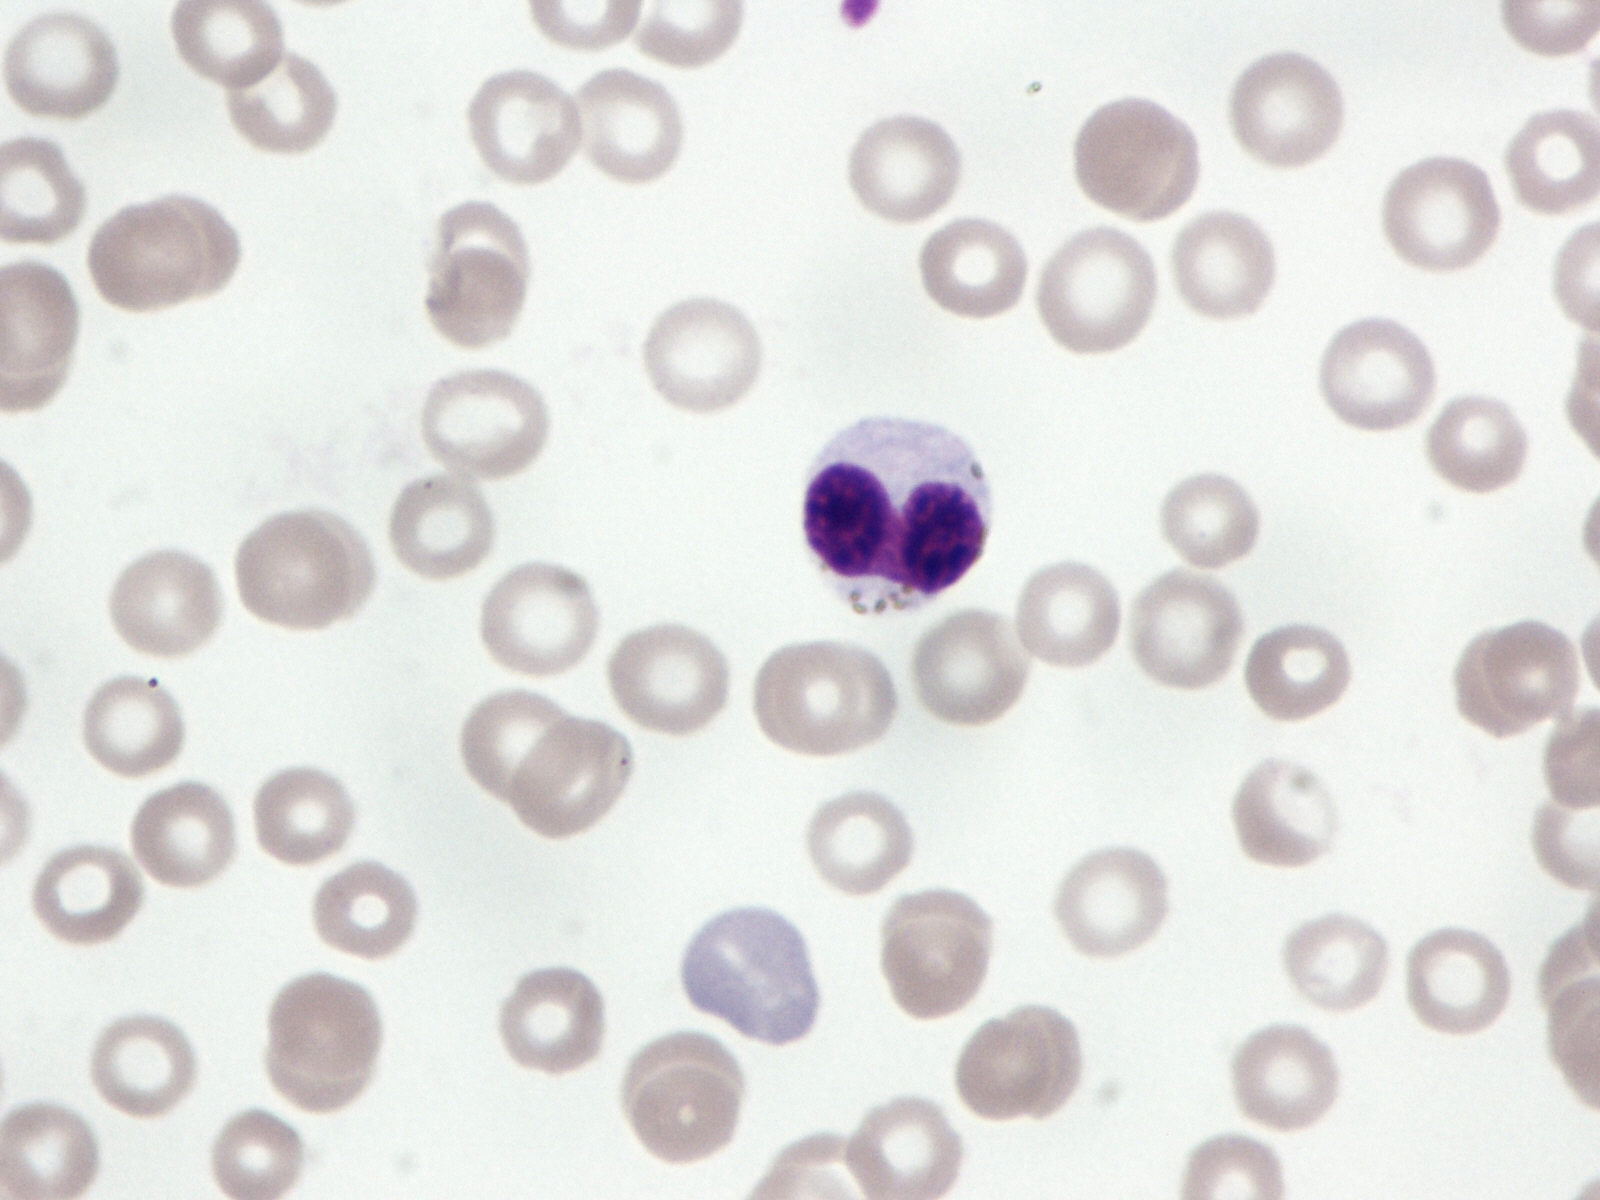

【15%OFFクーポン★3/13 00:00~3/16 23:59】ゴールドスタンダード 100% ホエイ プロテイン 【 iHerb アイハーブ 公式 】 オプティマムニュートリション Optimum Nutrition Gold Standard ホエイプロテイン パウダー ダブルリッチチョコレート 2.27kg
11,270円
87 customer ratings
4.44 ★★★★
製品仕様 商品名 ゴールドスタンダード 100% ホエイ プロテイン 【 iHerb アイハーブ 公式 】 オプティマムニュートリション Optimum Nutrition Gold Standard ホエイプロテイン パウダー ダブルリッチチョコレート 2.27kg 商品説明…

![【ポイント5倍 3/18 00:00-23:59】 [期間限定 LINE登録で1,000円OFF] VALX ホエイプロテイン WPC 1kg 選べる8種フレーバー 国内生産 山本義徳 チョコレート ベリー ヨーグルト カフェオレ バナナ 抹茶 プロテイン タンパク質 筋トレ ダイエット 美容 置き換え 女性](https://thumbnail.image.rakuten.co.jp/@0_mall/valx/cabinet/tmb/friend_pt5/wpc1kg_pt5.jpg?_ex=145x145)









![【先着順クーポン配布】【2個セット】大塚製薬 エクエル パウチ 120粒入り×2個[エクエル 大塚製薬 エクオール 大豆 更年期 乳酸菌 健康 美容 サプリ]■(追跡付)メール便専用商品■正規取扱店ヤマト](https://thumbnail.image.rakuten.co.jp/@0_mall/shimin2/cabinet/shohin_otsuka/03eqll/eqll_400-02.jpg?_ex=145x145)

![【 Lypo-C 公式 】リポ カプセル ビタミンC+D (28包入) ×1箱 リポソーム ビタミンC ビタミンD ビタミンD3 サプリ リポC リポソーム ビタミン [1包 ビタミンC&Dを効率良く吸収 国内製造] 液状 サプリメント 個包装](https://thumbnail.image.rakuten.co.jp/@0_mall/lypoc/cabinet/item/11432931/imgrc0091417505.jpg?_ex=145x145)



![送料無料【正規取扱店】大塚製薬 エクエル パウチ 120粒入り(約30日分)[エクエル 大塚製薬 エクエル 120 エクオール 薬局]正規販売店 / 正規品医療機関・調剤薬局 エクオール含有食品 日本郵便](https://thumbnail.image.rakuten.co.jp/@0_mall/shimin2/cabinet/shohin_otsuka/06086960/eqll_359-01.jpg?_ex=145x145)
